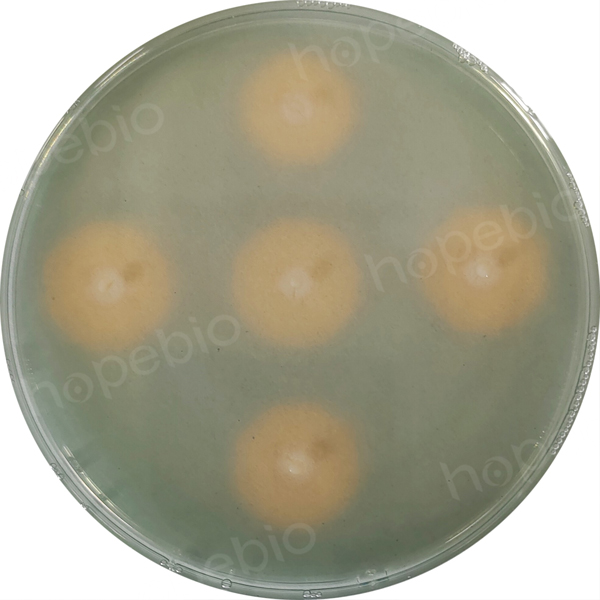

海博微信公众号
海博微信公众号
 海博天猫旗舰店
海博天猫旗舰店


 海博微信公众号
海博微信公众号
 海博天猫旗舰店
海博天猫旗舰店




一、氢氧化细菌和铁载体的简介:
氢氧化细菌(Hydrogen-oxidizing bacteria)是一类能通过氧化氢气获得能量,固定二氧化碳作为唯一碳源的微生物,土壤中分布广泛,尤其是豆科植物根际大量存在。氢氧化细菌没有单独的分类,多分布在假单胞菌属、副球菌属、黄杆菌属、分支杆菌属、产碱菌属、诺卡氏菌属、醋酸杆菌属及棒杆菌属等。绝大部分氢氧化细菌是兼性化能自养型,它们可以自养生长、异养生长、甚至混合营养生长,好氧或兼性厌氧。氢氧化细菌属于植物根际促生菌,在农作物增产方面有巨大的应用潜力,所以其各种促生机制的研究已成为热点,其中分泌铁载体就是几种重要的促生机制之一。
铁载体(siderophore)是一类能特异性结合铁离子并供给微生物细胞的低分子量物质。铁元素是微生物生长的必需元素,在缺铁的环境中微生物会分泌铁载体螯合铁离子满足自身生长需要。目前,常用的铁载体检测方法为Schwyn和Neilands发明的通用CAS琼脂平板法,当细菌产生的铁载体与由铬天青S(CAS)、十六烷基三甲基溴化铵(HDTMA)、铁离子组成的蓝色复合物结合后,会夺走铁离子,使细菌周围的培养基颜色由蓝色变为橘黄色,出现铁载体分泌圈,有利于判断细菌是否产生铁载体。
二、CAS检测培养基
1. 产品用途:用于细菌铁载体筛选试验。
2. 配方(mg/L):
|
铬天青S(CAS) |
60.5 |
|
十六烷基三甲基溴化铵(HDTMA) |
72.9 |
|
六水氯化铁 |
2.645 |
|
二水磷酸二氢钠 |
295.25 |
|
十二水磷酸氢二钠 |
1213.5 |
|
氯化铵 |
125 |
|
磷酸二氢钾 |
37.5 |
|
氯化钠 |
62.5 |
|
琼脂 |
9000 |
|
pH值6.8±0.1(25℃) |
|
三、试验方法:
1. 称取本品10.87g,加热煮沸完全溶解于1000mL蒸馏水中,分装三角瓶,116℃高压灭菌30分钟,冷却至50℃时,倾入无菌平皿,备用;
2. 用接种环挑取质控菌株新鲜培养物点种到平板上;
3. 放置35℃需氧培养24小时,记录试验结果。
四、试验结果判断:
接种以下质控菌株,放置于35℃需氧培养24小时。
|
质控菌株 |
菌株编号 |
接种量(CFU) |
参比或计数培养基 |
质控结果 |
|
铜绿假单胞菌 |
ATCC 9027 |
/ |
/ |
菌落周围有黄色环 |
图1 铜绿假单胞菌ATCC 9027在CAS检测培养基菌落特征
相关产品:
注:本文属海博生物原创,未经允许不得转载。
上一篇:YM琼脂培养基原理及实验现象
下一篇:营养琼脂培养基的原理和使用方法



